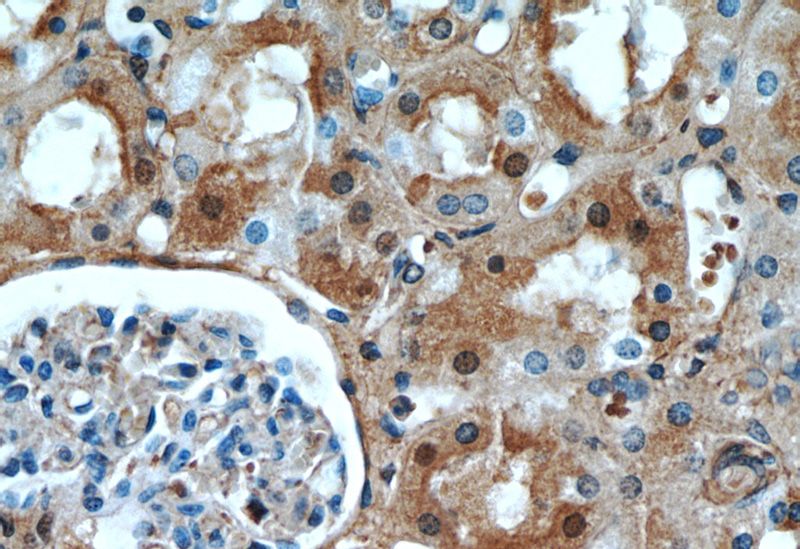
Immunohistochemical of paraffin-embedded human kidney using Catalog No:110752(FXR1 antibody) at dilution of 1:50 (under 40x lens)

-
Product Name
FXR1 antibody
- Documents
-
Description
FXR1 Rabbit Polyclonal antibody. Positive IF detected in Ethacrynic acid treated HepG2 cells, HepG2 cells. Positive IHC detected in human kidney tissue, human heart tissue. Positive WB detected in mouse testis tissue, HEK-293 cells, HeLa cells, mouse heart tissue, mouse liver tissue, NIH/3T3 cells. Positive IP detected in mouse skeletal muscle tissue. Observed molecular weight by Western-blot: 60-80 kDa
-
Tested applications
ELISA, WB, IHC, IP, IF
-
Species reactivity
Human,Mouse,Rat; other species not tested.
-
Alternative names
FXR1 antibody; hFXR1p antibody
- Immunogen
-
Isotype
Rabbit IgG
-
Preparation
This antibody was obtained by immunization of FXR1 recombinant protein (Accession Number: NM_001013438). Purification method: Antigen affinity purified.
-
Clonality
Polyclonal
-
Formulation
PBS with 0.1% sodium azide and 50% glycerol pH 7.3.
-
Storage instructions
Store at -20℃. DO NOT ALIQUOT
-
Applications
Recommended Dilution:
WB: 1:500-1:5000
IP: 1:200-1:2000
IHC: 1:20-1:200
IF: 1:10-1:100
-
Validations

mouse testis tissue were subjected to SDS PAGE followed by western blot with Catalog No:110752(FXR1 antibody) at dilution of 1:300

IP Result of anti-FXR1 (IP:Catalog No:110752, 3ug; Detection:Catalog No:110752 1:800) with mouse skeletal muscle tissue lysate 8000ug.
Immunohistochemical of paraffin-embedded human kidney using Catalog No:110752(FXR1 antibody) at dilution of 1:50 (under 40x lens)

Immunofluorescent analysis of Ethacrynic acid treated HepG2 cells using Catalog No:110752(FXR1 Antibody) at dilution of 1:25 and Rhodamine-Goat anti-Rabbit IgG
-
Background
Tumour necrosis factor-alpha (TNF-alpha) is a key mediator of inflammation in host defence against infection and in autoimmune disease. Its production is controlled post-transcriptionally by multiple RNA-binding proteins that interact with the TNF-alpha AU-rich element and regulate its expression; Fragile X mental retardation-related protein 1 (FXR1) is one of these. FXR1 (fragile-X-mental retardation-related protein 1) are RNA-binding proteins that have been demonstrated to impact miRNA-mediated, post-transcriptional gene regulation, and required for embryonic and postnatal development of muscle tissue. It can regulate intracellular transport and local translation of certain mRNAs
-
References
- Lewkowicz P, Cwiklińska H, Mycko MP. Dysregulated RNA-Induced Silencing Complex (RISC) Assembly within CNS Corresponds with Abnormal miRNA Expression during Autoimmune Demyelination. The Journal of neuroscience : the official journal of the Society for Neuroscience. 35(19):7521-37. 2015.
Related Products / Services
Please note: All products are "FOR RESEARCH USE ONLY AND ARE NOT INTENDED FOR DIAGNOSTIC OR THERAPEUTIC USE"
